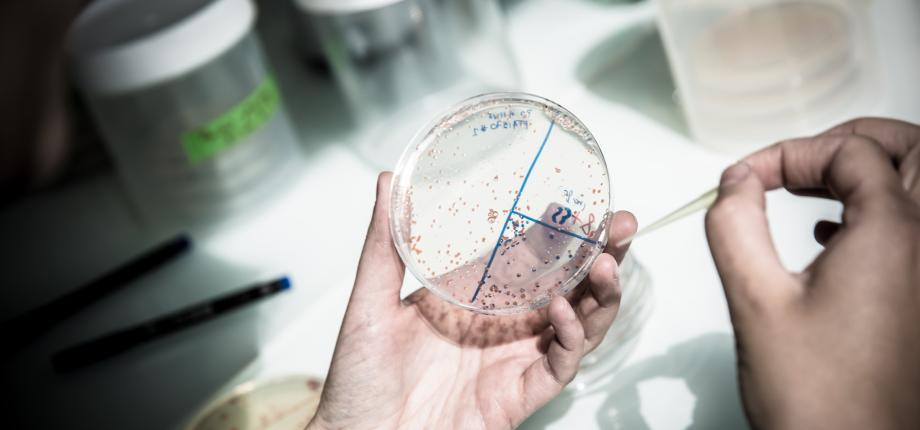

Enzyme mechanics, a lever for action against antimicrobial resistance
Hannu Myllykallio first became interested in the fight against antimicrobial resistance when he studied bacterial molecular adaptation to extreme environments. The research director at the Optics and Biosciences Laboratory* (LOB) has discovered that archaea** contain enzymes specific to DNA replication, which are also present in bacteria that are pathogenic to humans. "These thymidylate synthases, found in Mycobacterium tuberculosis and Helicobacter pylori, are involved in the synthesis of the letter T (thymine) in DNA", explains the scientist. Interestingly, they do not act in the same way in humans. It is therefore possible to envisage an antibiotic action by acting on thymidylates to disrupt DNA replication. "We have identified a candidate molecule that significantly inhibits the activity of these enzymes in mice", enthuses Hannu Myllykallio.
This thymidylate inhibitor was modeled in 3D and then put through the mill using an algorithm developed by the Computer Science Laboratory of the École Polytechnique (LIX***), specialists in artificial intelligence (AI). The aim is to optimize the structure and efficacy of the drug candidate. A start-up project surrounds this AI. It should offer real time savings in molecule development, and make up for the lack of profitability that has led pharmaceutical companies to disinvest in antibiotic design.
Helping bacteria repair their DNA
At the same time, the researcher and LOB post-doctoral fellow Rima Zein-Eddine are approaching the mechanisms of antibiotic resistance through the prism of fundamental research. "We know that Mycobacterium tuberculosis lives in the lungs and that each patient is infected by a unique strain. Genetic mixing is impossible. Yet the bacterium can develop antibiotic resistance. The only way it can do this is to modify its DNA from one generation to the next, to mutate," explains Hannu Myllykalllio. The scientists noted that the mutation rate was linked to the activity of another enzyme, NucS, this time involved in DNA repair. "We observed that if the enzyme's activity decreases, the DNA is not repaired or is repaired poorly, which increases the mutation rate. The bacteria then become more resistant".
Rima Zein-Eddine investigated further, dissecting 60,000 genetic sequences of Mycobacterium tuberculosis published in the Genbank database. "She identified over a hundred mutations in various DNA repair genes associated with antibiotic resistance. Most of these mutations affect the active sites of DNA repair enzymes, demonstrating that DNA repair is a marker of antibiotic resistance".
One way of combating antimicrobial resistance is therefore to maintain the repair activity of NucS despite the mutations, by adapting the molecules that interact with it to the new characteristics of its active site. "It's a path towards precision medicine, in which the antibiotic is specifically adapted to the patient, the strain that affects it and the mutation it carries". The fight against antimicrobial resistance has a bright future. All the more so as not all the mutations identified by Hannu Myllykallio and Rima Zein-Eddine have a significant impact on human health.
The weight of human activity
However, we must not lose sight of the role of climate change and human activities in the antimicrobial resistance phenomenon. "On the one hand, the widespread use of antibiotics and their dissemination in the environment are creating oxidative stress, the source of mutations in bacterial DNA. On the other, rising temperatures accelerate the metabolism of microorganisms, their multiplication, and the transmission of resistance genes between individuals. It's all interlinked".
** Archaea are single-celled microorganisms without nuclei or organelles, like prokaryotes (bacteria), but genetically close to eukaryotes (organisms whose cells have nuclei).
About:
Hannu Myllykallio is in charge of the “Molecular mechanisms of microbial adaptation” research theme at the Optics and Biosciences Laboratory at École Polytechnique. He obtained his PhD at the University of Pennsylvania, Philadelphia, studying biological energy conversion in photosynthetic bacteria, followed by postdoctoral research on microbial DNA replication and repair in the Paris region. He uses a wide range of computational and experimental methods to understand the molecular mechanisms underlying antimicrobial resistance and genome stability in prokaryotic cells.
*LOB: a joint research unit CNRS, Inserm, École Polytechnique, Institut Polytechnique de Paris, 91120 Palaiseau, France
***LIX: a joint research unit CNRS, École Polytechnique, Institut Polytechnique de Paris, 91120 Palaiseau, France